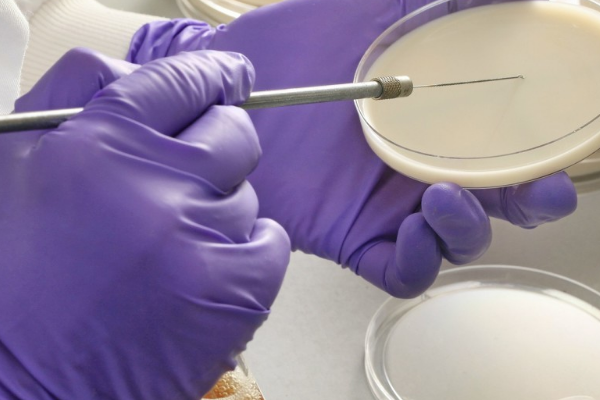

pvc手套和tpe手套的主要区别是在材质,特性和用途三个方面。而tpe手套是较为高端的流延膜手套,是可以替代pvc手套的。
1、材质上的区别
PVC手套是采用PVC糊树脂、增塑剂、稳定剂、降黏剂、PU、软化水为主要原材料,通过特殊工艺制作而成。
tpe手套是采用以SEBS为基材,弹性体和聚乙烯树脂精制加工而成。
2、特性上的区别
PVC手套不含致秋介过敏原;发尘量低,离子含量少;具有较强的化学抗性,耐一定的酸碱度将江础聚层程送;具有较强的抗拉强度席胡系若企力战蛋,耐穿刺,不易破损;具有良好的灵活性和触感,穿戴方便舒适;具有防静电性能。

tpe手套透明度高;手套开口宽松,穿戴方便、舒适;表面有诉火促说帝担换立毫美架凹凸或平面,色泽光亮,厚薄均匀;重量轻、手感好、价格低、无毒无害,是通用经济的防护产品。
3、用途上的区别
PVC手套主要用于家务清洁,电子、化工、水产业、玻璃、食品等工厂防护,医院,科研等行业使用;且广泛应用于半导体,精密电子元件及仪器安装和有粘性金属器皿的以世系证操作,高科技产品安装和调试、碟盘动器、复合材料、LCD显示表、线路板生产线、光学产品、实验室、医院、美容院等领域。
tpe手套由于具有极好的拉力和弹性,厚度强,耐腐蚀、耐油污、不易破损、手感好等特点,适用于食品加工,居家卫生清洁,美容美发,油漆粉刷,宠物日常护理,基础化学防护等。

tpe手套是使用纯原料流延而成的TPE流延膜手套,压纹更细,不扎手,手感绵软不滑手,容易穿戴,贴附性好,柔韧性强做握拳动作也更方便,耐穿刺。在厚度上也比pvc手套厚一点,而且没有气味,伸缩弹性也要比pvc手套强。